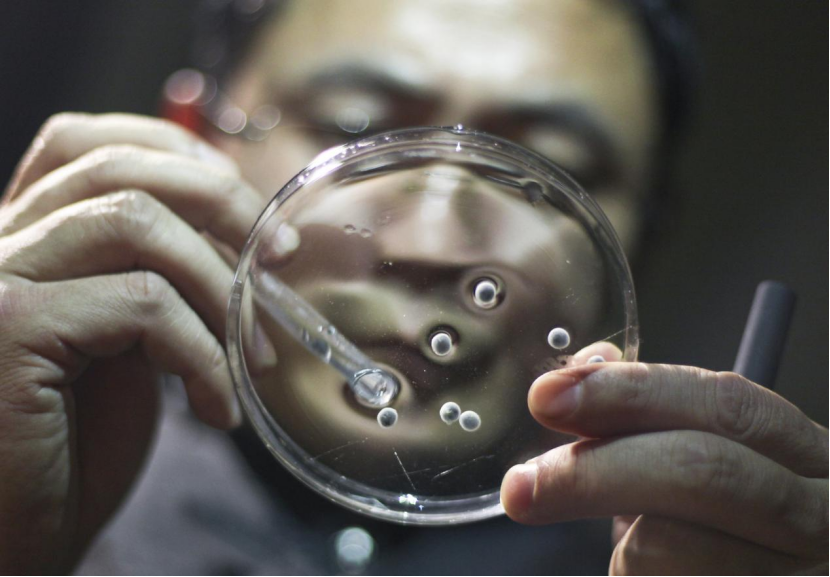

开栏语
江河奔涌,绿意盎然。深入学习贯彻习近平生态文明思想,三峡集团以实践为笔,以行动作答,从世界最大清洁能源走廊的澎湃动能,到长江大保护智慧治水的创新实践;从中华鲟繁衍的生命守护,到光伏治沙的生态方案;从绿色园区低碳转型,到美丽乡村“焕”新颜——三峡人以绿色足迹绘就“人与自然和谐共生”的时代画卷。
春暖花开时节,开设“绿色三峡行”专栏,在保护母亲河日聆听长江呼吸,于中国水周解读治水密码,在世界动植物保护日见证生命奇迹……借镜头定格一线故事,用笔尖传递绿色能量。
开栏语
江河奔涌,绿意盎然。深入学习贯彻习近平生态文明思想,三峡集团以实践为笔,以行动作答,从世界最大清洁能源走廊的澎湃动能,到长江大保护智慧治水的创新实践;从中华鲟繁衍的生命守护,到光伏治沙的生态方案;从绿色园区低碳转型,到美丽乡村“焕”新颜——三峡人以绿色足迹绘就“人与自然和谐共生”的时代画卷。
春暖花开时节,开设“绿色三峡行”专栏,在保护母亲河日聆听长江呼吸,于中国水周解读治水密码,在世界动植物保护日见证生命奇迹……借镜头定格一线故事,用笔尖传递绿色能量。